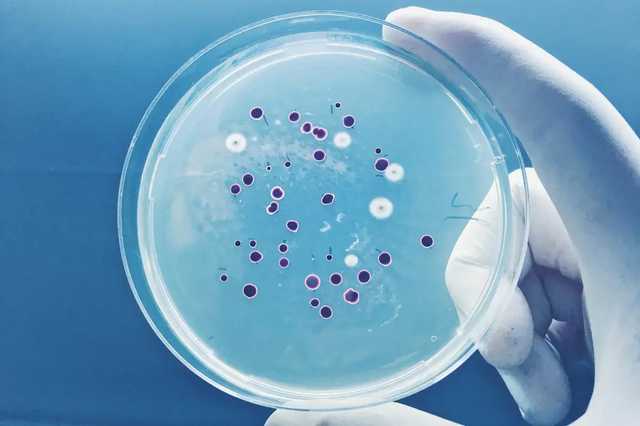
Российские ученые собираются «оживить» древние вирусы и бактерии из вечной мерзлоты

Российские ученые собираются «оживить» древние вирусы и бактерии из вечной мерзлоты
Российские ученые собираются «оживить» древние вирусы и бактерии из вечной мерзлоты
В России ученые из Института экспериментальной медицины собираются начать исследовать древние вирусы и бактерии, которые находятся в отложениях вечной мерзлоты. Об этом заявил доктор медицинских наук Артемий Гончаров в комментарии «ТАСС«.
Специалисты намерены извлечь древние микроорганизмы из отложений вечной мерзлоты возрастом около 200 тысяч лет. По мнению ученых, эти бактерии и вирусы могут помочь в создании новых антибиотиков.
«Мы попытаемся отыскать там (в Якутии) древние бактерии, и, что самое главное – древние вирусы древних бактерий – бактериофаги», – сказал Гончаров.
Он объяснил, что получить микроорганизмы можно после бурения там скважины и извлечения проб. Также ученый добавил, что начало работы запланировано на март. После отбора с пробами будут работать микробиологическими и молекулярно-генетическими методами.
По словам Гончарова, в дальнейшем их планируют переместить в Санкт-Петербург и работать над изучением в лабораторных условиях.
Теги: БактерииГончаров АртемВирусРоссия

Коментарі:
comments powered by DisqusЗагрузка...
Наші опитування
Показати результати опитування
Показати всі опитування на сайті











